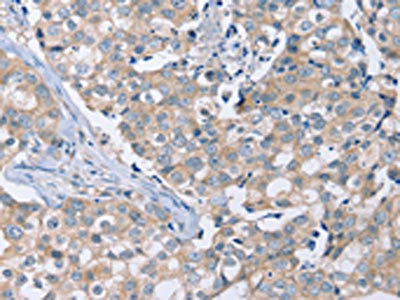

PEA15 Antibody
-
中文名稱:PEA15兔多克隆抗體
-
貨號:CSB-PA295602
-
規(guī)格:¥1100
-
圖片:
-
The image on the left is immunohistochemistry of paraffin-embedded Human prostate cancer tissue using CSB-PA295602(PEA15 Antibody) at dilution 1/20, on the right is treated with fusion protein. (Original magnification: ×200)
-
The image on the left is immunohistochemistry of paraffin-embedded Human breast cancer tissue using CSB-PA295602(PEA15 Antibody) at dilution 1/20, on the right is treated with fusion protein. (Original magnification: ×200)
-
-
其他:
產(chǎn)品詳情
-
Uniprot No.:
-
基因名:PEA15
-
別名:15 kDa phosphoprotein enriched in astrocytes antibody; Astrocytic phosphoprotein PEA 15 antibody; Astrocytic phosphoprotein PEA-15 antibody; Astrocytic phosphoprotein PEA15 antibody; HMAT 1 antibody; HMAT1 antibody; Homolog of mouse MAT 1 oncogene antibody; Homolog of mouse MAT1 oncogene antibody; HUMMAT 1H antibody; HUMMAT1H antibody; MAT 1 antibody; MAT 1H antibody; MAT1 antibody; MAT1H antibody; PEA 15 antibody; Pea15 antibody; PEA15 protein antibody; PEA15_HUMAN antibody; PED antibody; Phosphoprotein enriched in astrocytes 15 antibody; Phosphoprotein enriched in astrocytes 15kD antibody; Phosphoprotein enriched in diabetes antibody
-
宿主:Rabbit
-
反應(yīng)種屬:Human,Mouse,Rat
-
免疫原:Fusion protein of Human PEA15
-
免疫原種屬:Homo sapiens (Human)
-
標(biāo)記方式:Non-conjugated
-
抗體亞型:IgG
-
純化方式:Antigen affinity purification
-
濃度:It differs from different batches. Please contact us to confirm it.
-
保存緩沖液:-20°C, pH7.4 PBS, 0.05% NaN3, 40% Glycerol
-
產(chǎn)品提供形式:Liquid
-
應(yīng)用范圍:ELISA,IHC
-
推薦稀釋比:
Application Recommended Dilution ELISA 1:1000-1:2000 IHC 1:25-1:100 -
Protocols:
-
儲存條件:Upon receipt, store at -20°C or -80°C. Avoid repeated freeze.
-
貨期:Basically, we can dispatch the products out in 1-3 working days after receiving your orders. Delivery time maybe differs from different purchasing way or location, please kindly consult your local distributors for specific delivery time.
-
用途:For Research Use Only. Not for use in diagnostic or therapeutic procedures.
相關(guān)產(chǎn)品
靶點詳情
-
功能:Blocks Ras-mediated inhibition of integrin activation and modulates the ERK MAP kinase cascade. Inhibits RPS6KA3 activities by retaining it in the cytoplasm. Inhibits both TNFRSF6- and TNFRSF1A-mediated CASP8 activity and apoptosis. Regulates glucose transport by controlling both the content of SLC2A1 glucose transporters on the plasma membrane and the insulin-dependent trafficking of SLC2A4 from the cell interior to the surface.
-
基因功能參考文獻:
- Data suggest that PED has a prominent role in HCC biology. It acts particularly on promoting cell migration and confers resistance to sorafenib treatment. PMID: 29072691
- PP4 regulates breast cancer cell survival and identifies a novel PP4c-PEA15 signalling axis in the control of breast cancer cell survival. PMID: 27317964
- PEA15 expression was not significantly correlated with ovarian cancer antineoplastic drug resistance. PMID: 27669502
- Data suggest the role of the phospholipase C epsilon-Protein kinase D-PEA15 protein-ribosomal S6 kinase-IkappaB-NF-kappa B pathway in facilitating inflammation and inflammation-associated carcinogenesis in the colon. PMID: 27053111
- Integrin alpha5beta1 and p53 convergent pathways in the control of anti-apoptotic proteins PEA-15 and survivin in high-grade glioma. PMID: 26470725
- High PED expression is associated with esophageal carcinoma. PMID: 25775393
- The nuclear translocation of SApErk1/ 2 apart from PEA-15 as an important mechanism to reverse senescence phenotype. PMID: 25725291
- Latent HCMV infection of CD34 + cells protects cells from FAS-mediated apoptosis through the cellular IL-10/PEA-15 pathway. PMID: 25957098
- New therapeutic targets based around PEA-15 and its associated interactions are now being uncovered and could provide novel avenues for treatment strategies in multiple diseases. PMID: 24657708
- PED/PEA-15 overexpression is sufficient to block hydrogen peroxide-induced apoptosis in Ins-1E cells through a PLD-1 mediated mechanism PMID: 25489735
- Omi/HtrA2 overexpression promotes hepatocellular carcinoma cell apoptosis and the ped/pea-15 expression level causes this difference of the Omi/HtrA2 pro-apoptotic marker in the various hepatocellular carcinoma cell lines PMID: 25484138
- Results suggest that neurochemical adaptations of brain FADD, as well as its interaction with PEA-15, could play a major role to counteract the known activation of the mitochondrial apoptotic pathway in major depression PMID: 25075716
- Data show that phosphoprotein enriched in astrocytes of 15 kDa (PEA-15) influences dephosphorylation of epidermal growth factor receptor (EGFR) via extracellular signal-regulated kinases ERK1/2 sequestration in the cytoplasm. PMID: 25796184
- Tumor suppressor PEA15 is a regulator of genome integrity and is an integral component of the DNA damage response pathway. PMID: 24710276
- Up-regulated chaperone-mediated autophagy activity characteristic of most types of cancer cell enhances oncogenesis by shifting the balance of PED function toward tumor promotion. PMID: 24477641
- Our findings highlight the importance of pPEA-15 as a promising target for improving the efficacy of paclitaxel-based therapy in ovarian cancer. PMID: 23543364
- PEA-15 binding protects ERK2 from dephosphorylation, thus setting the stage for immediate ERK activity upon its release from the PEA-15 inhibitory complex PMID: 23575685
- study demonstrates that the PEA-15 protein decreases proliferation, clonogenicity, and invasiveness, but increases resistance to apoptosis in colorectal carcinoma cells PMID: 23481023
- The article hypothesizes that only unphosphorylated PEA-15 can act as a tumor-suppressor and that phosphorylation alters the interaction with binding partners to promote tumor development. PMID: 22694972
- NMR chemical shift perturbation and backbone dynamic studies at the fast ps-ns timescale of PED/PEA-15, in its free form and in the complex with ERK2. PMID: 22820249
- The 67 kD laminin receptor is a novel PED/PEA-15 interacting protein. PED/PEA-15 overexpression increases 67LR-mediated cell adhesion and migration to laminin and extracellular matrix invasion. PMID: 21895963
- the solution death effector domain (DED) structure of the PED/PEA-15 protein, a representative member of DED subfamily, using traditional NMR restraints with the addition of residual dipolar coupling restraints was refined. PMID: 22732408
- PEA15 impairs cell migration and correlates with clinical features predicting good prognosis in neuroblastoma PMID: 22213050
- Data show that knockdown of PEA-15 expression resulted in reversal of selumetinib-sensitive cells to resistant cells, implying that PEA-15 contributes to selumetinib sensitivity. PMID: 22144664
- Vitamin D3 signalling in the brain enhances the function of phosphoprotein enriched in astrocytes--15 kD (PEA-15) PMID: 19382910
- The protective effect of melatonin is likely mediated, in part, by inhibition of peroxynitrate-mediated nitrosative stress, which in turn relieves imbalance of mitochondrial HtrA2-PED signaling and endothelial cell death. PMID: 21198825
- There was no significant difference in the frequency of three marker haplotype in the PEA15 gene in patient with schizophrenia. PMID: 20537721
- The expressions of PED/PEA-15 and XIAP are elevated in hepatocellular carcinoma as compared with adjacent tissues and normal tissues. PMID: 20979872
- PED/PEA-15 modulates Coxsackievirus-adenovirus receptor expression and adenoviral entry, by sequestering ERK1/2. PMID: 20406097
- provide molecular basis of the PED/PEA-15 functional interactions and detailed surface for the design and development of PED/PEA-15 binders PMID: 20825483
- Data show that PED and Rac1 interact and that this interaction modulates cell migration/invasion processes in cancer cells through ERK1/2 pathway. PMID: 20648624
- The results show that HNF-4alpha serves as a scaffold protein for histone deacetylase activities, thereby inhibiting liver expression of genes including PED. PMID: 20396999
- PEA-15 promotes autophagy in glioma cells in a JNK-dependent manner PMID: 20452983
- Data show that PEA-15 prevents ERK1/2 localization to the plasma membrane, thereby inhibiting ERK1/2-dependent threonine phosphorylation of FRS2alpha to promote activation of the ERK1/2 MAP kinase pathway. PMID: 20032303
- Results suggest that PEA-15 expression is likely to be associated with the tumorigenesis of alignant pleural mesothelioma. PMID: 19771552
- role of mitogen-activated protein kinase family members in anti-apoptotic function PMID: 11790785
- role in modulating tumor necrosis factor-related apoptosis-inducing ligand-induced death-inducing signaling complex PMID: 11976344
- interaction with p90 ribosomal S6 kinase isoenzyme regulates its activity PMID: 12796492
- phosphorylation by Akt regulates the antiapoptotic function of PED/PEA-15 at least in part by controlling the stability of PED/PEA-15 PMID: 12808093
- apoptosis following Omi/HtrA2 mitochondrial release is mediated by reduction in ped/pea-15 cellular levels PMID: 15328349
- PEA-15 is inhibited by adenovirus E1A and has a role in ERK nuclear export and Ras-induced senescence PMID: 15331596
- The mechanism controlling PEA-15 binding to ERK/MAPK or FADD, and its subsequent role in cell proliferation and apoptosis is reported. PMID: 15916534
- Raised expression of the antiapoptotic protein pea-15 increases susceptibility to chemically induced skin tumor development PMID: 16044159
- Human breast cancer cells express high levels of PED and that AKT activity regulates PED protein levels. AKT-dependent increase of PED expression levels represents a key molecular mechanism for chemoresistance in breast cancer. PMID: 16061647
- cytoplasmic sequestration of the activated form of ERK by PEA15 enables the action of E1A in ovarian neoplasms PMID: 16170361
- Akt overactivation prevents the nuclear translocation of ERK1/2 and the AngII-induced proliferation through interaction with and stabilization of endogenous PEA-15. PMID: 16822839
- These data reveal a new function for PEA-15 in the inhibitory control of astrocyte motility through a PKC delta-dependent pathway involving the constitutive expression of a catalytic fragment of PKC delta. PMID: 16987961
- PEA15 overexpression represents a common defect in first degree relatives of patients with type 2 diabetes and is correlated with reduced insulin sensitivity in these individuals. PMID: 17021921
- TPA increases PED/PEA-15 expression at the post-translational level by inducing phosphorylation at serine 116 and preventing ubiquitinylation and proteosomal degradation PMID: 17227770
- In addition to sequestering protein kinases ERK1/2 in the cytoplasm, PEA-15 has the potential to modulate the activity of ERK2 in cells by competing directly with proteins that contain D-recruitment sites. PMID: 17658892
顯示更多
收起更多
-
亞細胞定位:Cytoplasm. Note=Associated with microtubules.
-
組織特異性:Ubiquitously expressed. Most abundant in tissues such as heart, brain, muscle and adipose tissue which utilize glucose as an energy source. Lower expression in glucose-producing tissues. Higher levels of expression are found in tissues from individuals wi
-
數(shù)據(jù)庫鏈接:
Most popular with customers
-
-
YWHAB Recombinant Monoclonal Antibody
Applications: ELISA, WB, IHC, IF, FC
Species Reactivity: Human, Mouse, Rat
-
Phospho-YAP1 (S127) Recombinant Monoclonal Antibody
Applications: ELISA, WB, IHC
Species Reactivity: Human
-
-
-
-
-